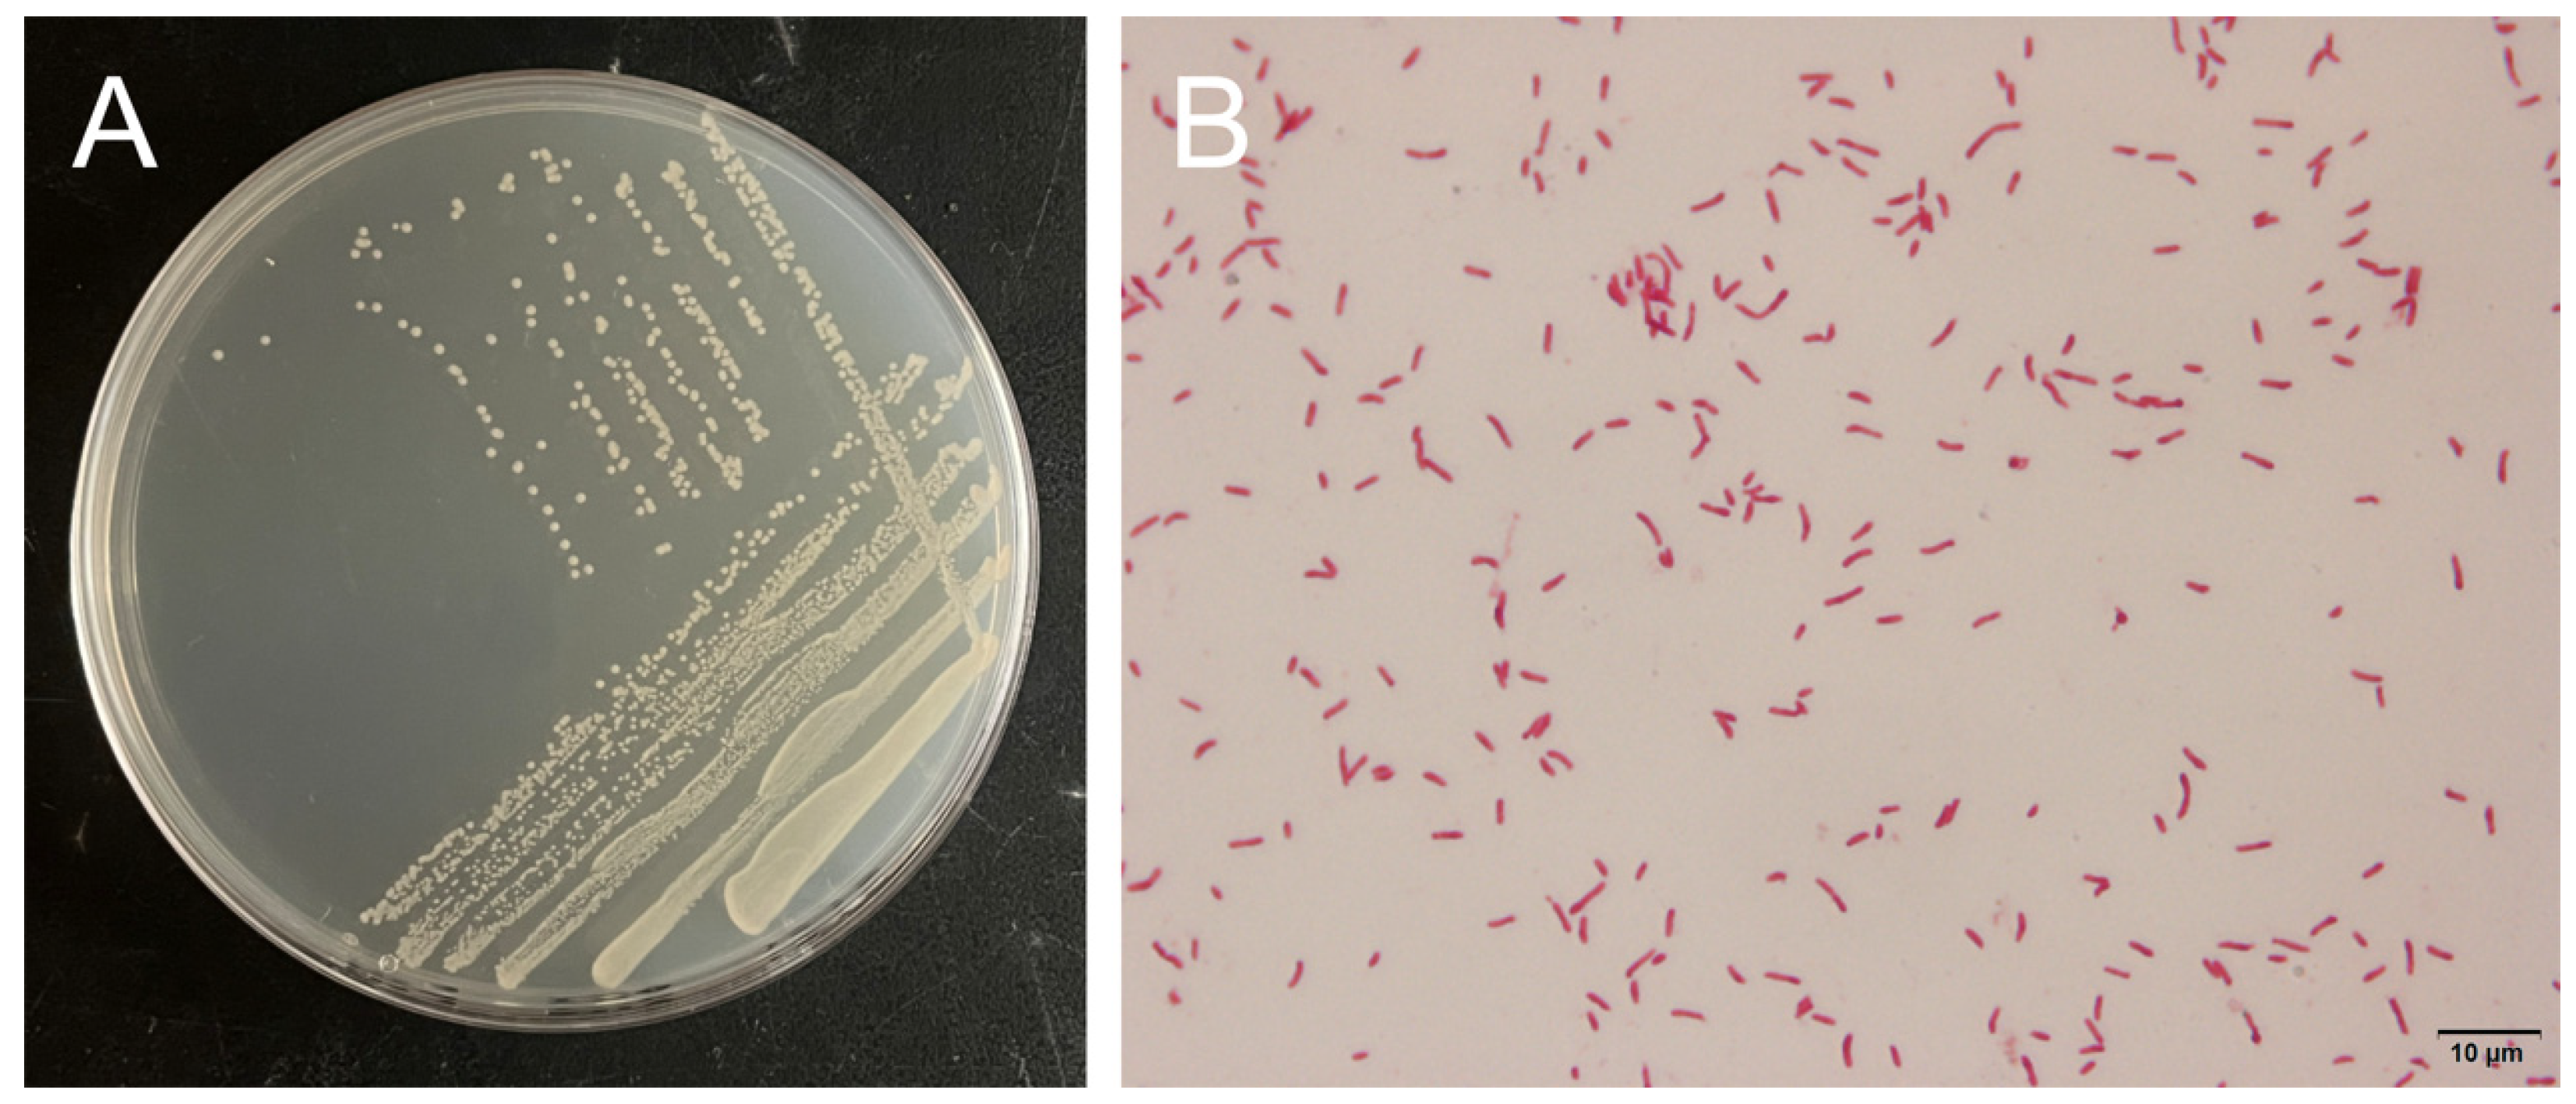
Microorganisms 13 00296 g005 Microorganisms 13 00296 g005

The Isolation and Identification of Pseudoalteromonas sp. H27, a Bacterial Strain Pathogenic to Crassostrea gigas
Abstract
1. Introduction
2. Materials and Methods
2.1. Sampling of Crassostrea gigas
2.2. Analysis of the Bacterial Community Structure in the Soft Tissue of C. gigas
2.3. Isolation of Culturable Bacteria from Diseased Tissue of C. gigas
2.4. Hemolysis Test
2.5. Identification of Bacterial Strains
2.5.1. Morphological Characterization
2.5.2. Molecular Identification Based on the Full-Length Sequence of 16S rRNA Gene
2.5.3. Metabolic Profiling and Antibiotics Sensitivity Analysis
2.6. Bacterial Challenge Experiment
2.7. Histopathological Observation
2.8. Data Processing and Analysis
3. Results
3.1. Clinical Signs of Naturally Diseased C. gigas
3.2. Bacterial Community Structure Analysis of the Soft Tissues in C. gigas
3.3. Isolation of Culturable Bacteria from Diseased C. gigas Tissues
3.4. Hemolytic Detection of Strain H27
3.5. Morphological Characterization and Molecular Identification of Strain H27
3.6. Metabolic Profiling and Antibiotic Sensitivity Analysis of Strain H27
3.7. Bacterial Challenge Experiment of Larval C. gigas Using Strain H27
3.8. Histopathological Analysis of Strain H27-Challenged C. gigas Adults
4. Discussion
5. Conclusions
Author Contributions
Funding
Institutional Review Board Statement
Informed Consent Statement
Data Availability Statement
Conflicts of Interest
References
- FAO. Fishery and Aquaculture Statistics—Yearbook 2021. In FAO Yearbook of Fishery and Aquaculture Statistics; FAO: Rome, Italy, 2024. [Google Scholar]
- Wang, D.; Gao, D. China Fishery Statistics Yearbook, 2024 ed; China Agriculture Press: Beijing, China, 2024. (In Chinese) [Google Scholar]
- Yang, J.; Wang, W.; Li, B.; Feng, Y.; Sun, G.; Li, Z.; Xu, X. Crassostrea gigas “Luyi No.1”. China Fish. Mon. 2021, 6, 87–94. (In Chinese) [Google Scholar]
- Chen, H.; Cai, J. The nutritional and medicinal value of oysters and their development and utilization. J. Chin. Med. Mater. 2005, 3, 172–174. (In Chinese) [Google Scholar] [CrossRef]
- Schets, F.M.; Van Den Berg, H.H.J.L.; Rutjes, S.A.; Husman, A.M.D.R. Pathogenic Vibrio species in dutch shellfish destined for direct human consumption. J. Food Prot. 2010, 73, 734–738. [Google Scholar] [CrossRef] [PubMed]
- Shan, C.; Li, M.; Liu, Z.; Xu, R.; Qiao, F.; Du, Z.Y.; Zhang, M.L. Pediococcus pentosaceus Enhances Host Resistance Against Pathogen by Increasing IL-1β Production: Understanding Probiotic Effectiveness and Administration Duration. Front. Immunol. 2021, 12, 766401. [Google Scholar] [CrossRef] [PubMed]
- Rippey, S.R. Infectious diseases associated with molluscan shellfish consumption. Clin. Microbiol. Rev. 1994, 7, 419–425. [Google Scholar] [CrossRef] [PubMed]
- Takahashi, K.G.; Nakamura, A.; Mori, K. Inhibitory Effects of Ovoglobulins on Bacillary Necrosis in Larvae of the Pacific Oyster, Crassostrea gigas. J. Invertebr. Pathol. 2000, 75, 212–217. [Google Scholar] [CrossRef] [PubMed]
- Clerissi, C.; Luo, X.; Lucasson, A.; Mortaza, S.; de Lorgeril, J.; Toulza, E.; Petton, B.; Escoubas, J.-M.; Dégremont, L.; Gueguen, Y.; et al. A core of functional complementary bacteria infects oysters in Pacific Oyster Mortality Syndrome. Anim. Microbiome 2023, 5, 26. [Google Scholar] [CrossRef] [PubMed]
- Petton, B.; Destoumieux-Garzón, D.; Pernet, F.; Toulza, E.; de Lorgeril, J.; Degremont, L.; Mitta, G. The Pacific Oyster Mortality Syndrome, a Polymicrobial and Multifactorial Disease: State of Knowledge and Future Directions. Front. Immunol. 2021, 12, 630343. [Google Scholar] [CrossRef]
- Destoumieux-Garzón, D.; Montagnani, C.; Dantan, L.; Nicolas, N.d.S.; Travers, M.-A.; Duperret, L.; Charrière, G.M.; Toulza, E.; Mitta, G.; Cosseau, C.; et al. Cross-talk and mutual shaping between the immune system and the microbiota during an oyster’s life. Philosophical Transactions of the Royal Society of London. Ser. B Biol. Sci. 2024, 379, 20230065. [Google Scholar]
- Gauthier, G.; Gauthier, M.; Christen, R. Phylogenetic analysis of the genera Alteromonas, Shewanella, and Moritella using genes coding for small-subunit rRNA sequences and division of the genus Alteromonas into two genera, Alteromonas (emended) and Pseudoalteromonas gen. nov., and proposal of twelve new species combinations. Int. J. Syst. Bacteriol. 1995, 45, 755–761. [Google Scholar]
- Ding, Y. Study on Quorum Sensing Properties and Molecular Regulation of Pseudoalteromonas spp. Master’s Thesis, Zhejiang University of Technology, Hangzhou, China, 2019. Available online: https://kns.cnki.net/kcms2/article/abstract?v=o5eMcsLgsI4yf7Hg35q_ASzoh8fSwzLe-4_XkLJ2e0up7qZDNT3jljeOFUhYXnHZ2OUk7w3K8uDK1G0_Duf0GzvZd5KFEMV6WJloiVkx4geynAF653FwtBUR8p_EoLG8zKHi8ecoKPyADDRzFpyg-A==&uniplatform=NZKPT&language=CHS (accessed on 7 February 2023). (In Chinese).
- Rong, J. Genome Sequencing and Comparative Genomics of the Marine Bacterial Genus Pseudoalteromonas. Ph.D. Thesis, Shandong University, Jinan, China, 2016. Available online: https://kns.cnki.net/kcms2/article/abstract?v=5DzVwdTmeh-zNQMeQT8CrRKbRxxsiuuHFmkM5oC60pdA0Ca49D1jTHqIY_4_4LnJVo_qSDCFXlgyA6naGlZcnG4uod-S3dLlU5_MRffB04gGf74_o0lXHcrb1HgVxc4KX5bmy0NIIkNy3qCFwx4cKw==&uniplatform=NZKPT&language=CHS (accessed on 13 November 2023). (In Chinese).
- Lovejoy, C.; Bowman, J.P.; Hallegraeff, G.M. Algicidal effects of a novel marine Pseudoalteromonas isolate (class Proteobacteria, gamma subdivision) on harmful algal bloom species of the genera Chattonella, Gymnodinium, and Heterosigma. Appl. Environ. Microbiol. 1998, 64, 2806–2813. [Google Scholar] [CrossRef] [PubMed]
- Huang, Z.; Li, C.; Yu, X.; Liao, W.; Sun, J.; Peng, M. Isolation of a Strain of Pseudoalteromonas sp. and the Study on the Characteristics of its Algicidal Effect. Ocean Technol. 2008, 3, 56–60. (In Chinese) [Google Scholar]
- Bai, X.; Zhang, X.; Bi, K.; Fan, X.; Yan, B.; Qin, G. Isolation and identification of a Pseudoalteromonas. Jiangsu Agric. Sci. 2013, 41, 211–216. (In Chinese) [Google Scholar] [CrossRef]
- Costa-Ramos, C.; Rowley, A.F. Effect of extracellular products of Pseudoalteromonas atlantica on the edible crab Cancer pagurus. Appl. Environ. Microbiol. 2004, 70, 729–735. [Google Scholar] [CrossRef] [PubMed]
- Li, J.; Mou, Z.; Yang, H.; Mao, Y.; Yan, Y.; Mo, Z. Isolation and Identification the Pathogen of Pyropia yezoensis Green Spot Disease. Prog. Fish. Sci. 2019, 40, 140–146. (In Chinese) [Google Scholar] [CrossRef]
- Yan, Y.; Ma, J.; Xu, P.; Sun, Q.; Wang, H. Pseudoalteromonas citrea, the causative agent of green-spot disease of Porphyrae yezoensis. J. Fish. Sci. China 2002, 4, 353–358. (In Chinese) [Google Scholar]
- Wang, H.; Li, X.; Xia, Y.; Yan, B. Isolation, identification and biological pathogen of yellow spot disease in conchocelis of Porphyra yezoensis. Mar. Environ. Sci. 2011, 30, 361–364+408. (In Chinese) [Google Scholar]
- Sawabe, T.; Makino, H.; Tatsumi, M.; Nakano, K.; Tajima, K.; Iqbal, M.M.; Yumoto, I.; Ezura, Y.; Christen, R. Pseudoalteromonas bacteriolytica sp. nov., a marine bacterium that is the causative agent of red spot disease of Laminaria japonica. Int. J. Syst. Bacteriol. 1998, 48 Pt 3, 769–774. [Google Scholar] [CrossRef]
- Sawabe, T.; Tanaka, R.; Iqbal, M.M.; Tajima, K.; Ezura, Y.; Ivanova, E.P.; Christen, R. Assignment of Alteromonas elyakovii KMM 162T and five strains isolated from spot-wounded fronds of Laminaria japonica to Pseudoalteromonas elyakovii comb. nov. and the extended description of the species. Int. J. Syst. Evol. Microbiol. 2000, 50 Pt 1, 265–271. [Google Scholar] [CrossRef]
- Sun, S. Study on the Major Bacterial Diseases of Cultured Sea Cucumber (Aposticchopus japonicus) During Larval Stages. Master’s Thesis, Ocean University of China, Qingdao, China, 2007. Available online: https://kns.cnki.net/kcms2/article/abstract?v=2Wn7gbiy3W8QCqFgVqp86NcPeUDo7KYacuCZ1Tu0QxGctshe7JI8bl5zEU7hqa1CGZMz8UPoVz4qV5BCAMO14ksxg3a-jNGmJ1dlnoh-r6Tv-EWCfvJr2VYhvv8UmlF-pmYAL3dfyOVjiNPfSo4x0g==&uniplatform=NZKPT&language=CHS (accessed on 1 December 2023). (In Chinese).
- Liu, H.; Zheng, F.; Sun, X.; Hong, X.; Dong, S.; Wang, B.; Tang, X.; Wang, Y. Identification of the pathogens associated with skin ulceration and peristome tumescence in cultured sea cucumbers Apostichopus japonicus (Selenka). J. Invertebr. Pathol. 2010, 105, 236–242. [Google Scholar] [CrossRef] [PubMed]
- Xie, J.; Wang, Y.; Zhang, Z.; Rong, X. Rapid detection of two pathogens of skin ulcer syndrome in cultured Apostichopus japonicus by Dot-ELISA. Mar. Sci.-Qingdao-Chin. Ed. 2007, 8, 59–64. (In Chinese) [Google Scholar]
- Fang, B. Epidemiological and Aetiological Studies on the Skin Ulcerative Syndrome of Cultured Sea Cucumber Apostichopus japonicus and Analysis of the Pathogen’s Reservoir. Master’s Thesis, Ocean University of China, Qingdao, China, 2007. Available online: https://kns.cnki.net/kcms2/article/abstract?v=2Wn7gbiy3W9ksoBcCPSspMXml3DpWEKx40GVbgOnAfOp2eUcILaUaa3RH3cSHP2dro-QiVSYmd-ngYQEcZtiYP3S7cKnwPIXG5olGyY-mARcuEh_lpePJeZ59K-B31TV590WaG0UVRHRvYQ8nltkAQ==&uniplatform=NZKPT&language=CHS (accessed on 1 December 2023). (In Chinese).
- Wang, Y.; Feng, N.; Li, Q.; Ding, J.; Zhan, Y.; Chang, Y. Isolation and characterization of bacteria associated with a syndrome disease of sea urchin Strongylocentrotus intermedius in North China. Aquac. Res. 2013, 44, 691–700. [Google Scholar] [CrossRef]
- Qiao, Y.; Shen, H.; Wan, X.; Qi, Y.; Wang, L. The identification of a pathogenic Pseudoalteromonas that causes disease in black seabream and the analysis of its virulence genes. Jiangsu Agric. Sci. 2015, 43, 229–233. (In Chinese) [Google Scholar] [CrossRef]
- Qiao, Q.; Han, N.; Chen, C.; Yang, Z.; Shi, C.; Huang, J.; Li, Q. Isolation and identification of pathogenic Pseudoalteromonas sp. and antibiotic sensitivity research. J. Anhui Agric. Sci. 2010, 38, 14224–14226+14232. (In Chinese) [Google Scholar] [CrossRef]
- Bao, Y.; Shang, Y.; Wang, H.; Yuan, Z. Isolation and Identification of Pathogenic Pseudoalteromonas from Cynoglossus semilaevis Günther and Its Drug Sensitivity Analysis. Anhui Agric. Sci. 2020, 48, 102–105+123. (In Chinese) [Google Scholar]
- Pujalte, M.J.; Sitjà-Bobadilla, A.; Macián, M.C.; Álvarez-Pellitero, P.; Garay, E. Occurrence and virulence of Pseudoalteromonas spp. in cultured gilthead sea bream (Sparus aurata L.) and European sea bass (Dicentrarchus labrax L.). Molecular and phenotypic characterisation of P. undina strain U58. Aquaculture 2007, 271, 47–53. [Google Scholar] [CrossRef]
- Worden, P.J.; Bogema, D.R.; Micallef, M.L.; Go, J.; Deutscher, A.T.; Labbate, M.; Green, T.J.; King, W.L.; Liu, M.; Seymour, J.R.; et al. Phylogenomic diversity of Vibrio species and other Gammaproteobacteria isolated from Pacific oysters (Crassostrea gigas) during a summer mortality outbreak. Microb. Genom. 2022, 8, mgen000883. [Google Scholar] [CrossRef] [PubMed]
- Zhang, X.; Huang, B.-W.; Zheng, Y.-D.; Xin, L.S.; Chen, W.B.; Yu, T.; Li, C.; Wang, C.M.; Bai, C.M. Identification and Characterization of Infectious Pathogens Associated with Mass Mortalities of Pacific Oyster (Crassostrea gigas) Cultured in Northern China. Biology 2023, 12, 759. [Google Scholar] [CrossRef] [PubMed]
- Del Sal, G.; Manfioletti, G.; Schneider, C. The CTAB-DNA precipitation method: A common mini-scale preparation of template DNA from phagemids, phages or plasmids suitable for sequencing. BioTechniques 1989, 7, 514–520. [Google Scholar]
- Schloss, P.D.; Westcott, S.L.; Ryabin, T.; Ryabin, T.; Hall, J.R.; Hartmann, M.; Hollister, E.B.; Lesniewski, R.A.; Oakley, B.B.; Parks, D.H.; et al. Introducing mothur: Open-Source, Platform-Independent, Community-Supported Software for Describing and Comparing Microbial Communities. Appl. Environ. Microbiol. 2009, 75, 7537–7541. [Google Scholar] [CrossRef]
- Jensen, S.; Bergh, O.; Enger, O.; Hjeltnes, B. Use of PCR-RFLP for genotyping 16S rRNA and characterizing bacteria cultured from halibut fry. Can. J. Microbiol. 2002, 48, 379–386. [Google Scholar] [CrossRef]
- Cheng, C.; Yang, M.; Li, J.; Yao, S.; Hu, H. Biolog Microbial Identification System—Study on the Operating Regulation of Bacteria Identification. Food Ferment. Ind. 2006, 32, 50. (In Chinese) [Google Scholar]
- Wendling, C.C.; Batista, F.M.; Wegner, K.M. Persistence, Seasonal Dynamics and Pathogenic Potential of Vibrio Communities from Pacific Oyster Hemolymph. PLoS ONE 2014, 9, e94256. [Google Scholar] [CrossRef]
- Ushijima, B.; Saw, J.H.; Videau, P.; Häse, C.C. Comparison of Vibrio coralliilyticus virulence in Pacific oyster larvae and corals. Microbiology 2022, 168, 001169. [Google Scholar] [CrossRef] [PubMed]
- King, W.L.; Jenkins, C.; Seymour, J.R.; Labbate, M. Oyster disease in a changing environment: Decrypting the link between pathogen, microbiome and environment. Mar. Environ. Res. 2019, 143, 124–140. [Google Scholar] [CrossRef] [PubMed]
- Nagaraj, V.; Skillman, L.; Li, D.; Xie, Z.; Ho, G. Culturable bacteria from a full-scale desalination plant: Identification methods, bacterial diversity and selection of models based on membrane-biofilm community. Desalination 2019, 457, 103–114. [Google Scholar] [CrossRef]
- Canesi, L.; Pruzzo, C. Chapter 6—Specificity of Innate Immunity in Bivalves: A Lesson From Bacteria. In Lessons in Immunity; Ballarin, L., Cammarata, M., Eds.; Academic Press: Cambridge, MA, USA, 2016; pp. 79–91. [Google Scholar]
- Paillard, C.; Le Roux, F.; Borrego, J.J. Bacterial disease in marine bivalves, a review of recent studies: Trends and evolution. Aquat. Living Resour. 2004, 17, 477–498. [Google Scholar] [CrossRef]
- Choudhury, J.D.; Pramanik, A.; Webster, N.S.; Llewellyn, L.E.; Gachhui, R.; Mukherjee, J. The Pathogen of the Great Barrier Reef Sponge Rhopaloeides odorabile Is a New Strain of Pseudoalteromonas agarivorans Containing Abundant and Diverse Virulence-Related Genes. Mar. Biotechnol. 2015, 17, 463–478. [Google Scholar] [CrossRef] [PubMed]
- Li, M.; Wu, W.; You, W.; Huang, S.; Huang, M.; Luo, X.; Lu, Y.; Ke, C.; Xie, Q. A novel screening method for the detection of Pseudoalteromonas shioyasakiensis, an emerging opportunistic pathogen that caused the mass mortality of juvenile Pacific abalone (Haliotis discus hannai) during a record-breaking heat wave. Aquaculture 2021, 545, 737191. [Google Scholar] [CrossRef]
- Miranda, C.D.; Rojas, R.; Geisse, J.; Romero, J.; González-Rocha, G. Scallop larvae hatcheries as source of bacteria carrying genes encoding for non-enzymatic phenicol resistance. Mar. Pollut. Bull. 2015, 95, 173–182. [Google Scholar] [CrossRef] [PubMed]
- Garnier, M.; Labreuche, Y.; Garcia, C.; Robert, M.; Nicolas, J.-L. Evidence for the involvement of pathogenic bacteria in summer mortalities of the Pacific oyster Crassostrea gigas. Microb. Ecol. 2007, 53, 187–196. [Google Scholar] [CrossRef] [PubMed]
- Zaroogian, G.; Yevich, P. The nature and function of the brown cell in Crassostrea virginica. Mar. Environ. Res. 1994, 37, 355–373. [Google Scholar] [CrossRef]
- Bueno, R.; Perrott, M.; Dunowska, M.; Brosnahan, C.; Johnston, C. In situ hybridization and histopathological observations during ostreid herpesvirus-1-associated mortalities in Pacific oysters Crassostrea gigas. Dis. Aquat. Org. 2016, 122, 43–55. [Google Scholar] [CrossRef]
- Ivanova, E.P.; Sawabe, T.; Lysenko, A.M.; Gorshkova, N.M.; Hayashi, K.; Zhukova, N.V.; Nicolau, D.V.; Christen, R.; Mikhailov, V.V. Pseudoalteromonas translucida sp. nov. and Pseudoalteromonas paragorgicola sp. nov., and emended description of the genus. Int. J. Syst. Evol. Microbiol. 2002, 52 Pt 5, 1759–1766. [Google Scholar] [CrossRef] [PubMed][Green Version]
- Xi, Y.; Zhu, D.; Liu, H.; Han, Z. Advances on Pseudoalteromonas species and their extracellular bioactive compounds. Microbiology 2005, 3, 108–112. (In Chinese) [Google Scholar] [CrossRef]
- Offret, C.; Desriac, F.; Le Chevalier, P.; Mounier, J.; Jégou, C.; Fleury, Y. Spotlight on Antimicrobial Metabolites from the Marine Bacteria Pseudoalteromonas: Chemodiversity and Ecological Significance. Mar. Drugs 2016, 14, 129. [Google Scholar] [CrossRef] [PubMed]
- Go, J.; Deutscher, A.T.; Spiers, Z.B.; Dahle, K.; Kirkland, P.D.; Jenkins, C. Mass mortalities of unknown aetiology in Pacific oysters Crassostrea gigas in Port Stephens, New South Wales, Australia. Dis. Aquat. Org. 2017, 125, 227–242. [Google Scholar] [CrossRef] [PubMed]
- Larsen, A.K.; Nymo, I.H.; Sørensen, K.K.; Seppola, M.; Rødven, R.; de Bagüés, M.P.J.; Al Dahouk, S.; Godfroid, J. Concomitant Temperature Stress and Immune Activation may Increase Mortality Despite Efficient Clearance of an Intracellular Bacterial Infection in Atlantic Cod. Front. Microbiol. 2018, 9, 2963. [Google Scholar] [CrossRef]

| Reaction Item | Result | Reaction Item | Result | ||
|---|---|---|---|---|---|
| A1 | Negative Control | - | E1 | Gelatin | + |
| A2 | Dextrin | + | E2 | Glycyl-L-Proline | + |
| A3 | D-Maltose | + | E3 | L-Alanine | + |
| A4 | D-Trehalose | - | E4 | L-Arginine | + |
| A5 | D-Cellobiose | - | E5 | L-Aspartic Acid | - |
| A6 | Gentiobiose | - | E6 | L-Glutamic Acid | + |
| A7 | Sucrose | - | E7 | L-Histidine | - |
| A8 | D-Turanose | - | E8 | L-Pyroglutamic Acid | - |
| A9 | Stachyose | - | E9 | L-Serine | + |
| A10 | Positive Control | + | E10 | Lincomycin | - |
| A11 | pH 6 | + | E11 | Guanidine HCl | - |
| A12 | pH 5 | - | E12 | Niaproof4 | - |
| B1 | D-Raffinose | - | F1 | Pectin | - |
| B2 | α-D-Lactose | - | F2 | D-Galacturonic Acid | + |
| B3 | D-Melibiose | - | F3 | L-Galactonic Acid Lactone | + |
| B4 | β-Methyl-D-Glucoside | - | F4 | D-Gluconic Acid | + |
| B5 | D-Salicin | - | F5 | D-Glucuronic Acid | + |
| B6 | N-Acetyl-D-Glucosamine | + | F6 | Glucuronamide | + |
| B7 | N-Acetyl-β-D-Mannosamine | + | F7 | Mucic Acid | - |
| B8 | N-Acetyl-D-Galactosamine | - | F8 | Quinic Acid | - |
| B9 | N-Acetyl Neuraminic Acid | + | F9 | D-Saccharic Acid | - |
| B10 | 1%NaCl | + | F10 | Vancomycin | + |
| B11 | 4%NaCl | + | F11 | Tetrezolium Violet | + |
| B12 | 8%NaCl | + | F12 | Tetrezolium Blue | - |
| C1 | α-D-Glucose | + | G1 | p-Hydroxy-Phenylacetic Acid | - |
| C2 | D-Mannose | - | G2 | Methyl Pyruvate | - |
| C3 | D-Fructose | + | G3 | D-Lactic Acid Methyl Ester | - |
| C4 | D-Galactose | + | G4 | L-Lactic Acid | - |
| C5 | 3-Methyl Glucose | - | G5 | Citric Acid | - |
| C6 | D-Fucose | - | G6 | α-Keto-Glutaric Acid | - |
| C7 | L-Fucose | - | G7 | D-Malic Acid | - |
| C8 | L-Rhamnose | - | G8 | L-Malic Acid | + |
| C9 | Inosine | + | G9 | Bromo-Succinic Acid | - |
| C10 | 1% Sodium Lactate | + | G10 | Nalidixic Acid | - |
| C11 | Fusidic Acid | + | G11 | Lithium Chloride | - |
| C12 | D-Serine | - | G12 | Potassium Tellurite | + |
| D1 | D-Sorbitol | - | H1 | Tween 40 | - |
| D2 | D-Mannitol | + | H2 | γ-Amino-Butyric Acid | - |
| D3 | D-Arabitol | - | H3 | α-Hydroxy-Butyric Acid | - |
| D4 | myo-Inositol | - | H4 | β-Hydroxy-D,L-butyric Acid | - |
| D5 | Glycerol | - | H5 | α-Keto-Butyric Acid | - |
| D6 | D-Glucose-6-PO4 | + | H6 | Acetoacetic Acid | + |
| D7 | D-Fructose-6-PO4 | + | H7 | Propionic Acid | + |
| D8 | D-Aapartic Acid | - | H8 | Acetic Acid | + |
| D9 | D-Serine | - | H9 | Formic Acid | - |
| D10 | Troleandomycin | - | H10 | Aztreonam | + |
| D11 | Rifamycin SV | - | H11 | Sodium Butyrate | - |
| D12 | Minocycline | - | H12 | Sodium Bromate | - |
| Type of Antibiotic | Name of Antibiotic | Inhibitory Zone Diameter (mm) | Inhibitory Zone Diameter of H27 (mm) | Sensitivity | ||
|---|---|---|---|---|---|---|
| R | I | S | ||||
| β-lactams | Cefalexin | ≤14 | 15–17 | ≥18 | 0 | R |
| Ceftriaxone | ≤13 | 20–22 | ≥23 | 25.73 ± 0.40 | S | |
| Penicillin | ≤19 | ≥20 | 13.23 ± 0.45 | R | ||
| Amoxicillin | ≤13 | 14–17 | ≥18 | 20.90 ± 1.32 | S | |
| Aminoglycosides | Neomycin | ≤12 | 13–16 | ≥17 | 15.43 ± 2.72 | I |
| Kanamycin | ≤13 | 14–17 | ≥18 | 7.83 ± 0.90 | R | |
| Streptomycin | ≤11 | 12–14 | ≥15 | 16.53 ± 0.32 | S | |
| Gentamicin | ≤12 | 13–14 | ≥15 | 31.23 ± 1.50 | S | |
| Macrolides | Erythromycin | ≤13 | 14–22 | ≥23 | 18.20 ± 1.15 | I |
| Clarithromycin | ≤13 | 14–17 | ≥18 | 18.73 ± 0.67 | S | |
| Azithromycin | ≤13 | 14–17 | ≥18 | 21.63 ± 2.87 | S | |
| Quinolones | Norfloxacin | ≤12 | 13–16 | ≥17 | 24.93 ± 0.58 | S |
| Ofloxacin | ≤12 | 13–15 | ≥16 | 21.13 ± 0.12 | S | |
| Sulfonamides | Cotrimoxazole | ≤10 | 11–15 | ≥16 | 19.53 ± 1.26 | S |
| Tetracyclines | Tetracyclines | ≤14 | 15–18 | ≥19 | 7.87 ± 0.50 | R |
| Chloramphenicols | Chloromycetin | ≤12 | 13–17 | ≥18 | 26.63 ± 2.33 | S |
| Florfenicol | ≤12 | 13–17 | ≥18 | 25.90 ± 0.44 | S | |
| Polypeptides | PolymyxinB | ≤8 | 9–11 | ≥12 | 17.73 ± 1.14 | S |
| Nitrofurans | Furazolidone | ≤14 | 15–16 | ≥17 | 12.93 ± 2.58 | R |
Disclaimer/Publisher’s Note: The statements, opinions and data contained in all publications are solely those of the individual author(s) and contributor(s) and not of MDPI and/or the editor(s). MDPI and/or the editor(s) disclaim responsibility for any injury to people or property resulting from any ideas, methods, instructions or products referred to in the content. |
© 2025 by the authors. Licensee MDPI, Basel, Switzerland. This article is an open access article distributed under the terms and conditions of the Creative Commons Attribution (CC BY) license (https://creativecommons.org/licenses/by/4.0/).
Share and Cite
Qin, H.; Jiang, J.; Jing, Z.; Wang, J.; Xu, S.; Chen, R.; Wang, B.; Huo, Z.; Fang, L. The Isolation and Identification of Pseudoalteromonas sp. H27, a Bacterial Strain Pathogenic to Crassostrea gigas. Microorganisms 2025, 13, 296. https://doi.org/10.3390/microorganisms13020296
Qin H, Jiang J, Jing Z, Wang J, Xu S, Chen R, Wang B, Huo Z, Fang L. The Isolation and Identification of Pseudoalteromonas sp. H27, a Bacterial Strain Pathogenic to Crassostrea gigas. Microorganisms. 2025; 13(2):296. https://doi.org/10.3390/microorganisms13020296
Chicago/Turabian StyleQin, Heyang, Junyi Jiang, Zhikai Jing, Jiayu Wang, Shuang Xu, Rongwei Chen, Bo Wang, Zhongming Huo, and Lei Fang. 2025. "The Isolation and Identification of Pseudoalteromonas sp. H27, a Bacterial Strain Pathogenic to Crassostrea gigas" Microorganisms 13, no. 2: 296. https://doi.org/10.3390/microorganisms13020296
APA StyleQin, H., Jiang, J., Jing, Z., Wang, J., Xu, S., Chen, R., Wang, B., Huo, Z., & Fang, L. (2025). The Isolation and Identification of Pseudoalteromonas sp. H27, a Bacterial Strain Pathogenic to Crassostrea gigas. Microorganisms, 13(2), 296. https://doi.org/10.3390/microorganisms13020296





